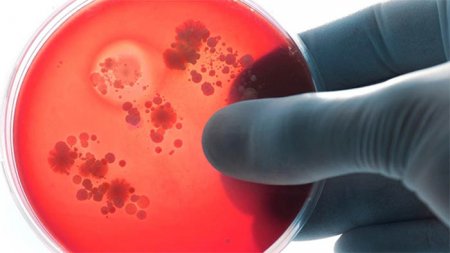

Менингококкты инфекциясы жайлы
Менингококкты инфекциясы – Neisseria meningitidis бактериясы тудыратын аса қауіпті инфекциялық ауру.
Менингококты инфекциясының ауырлық дәрежесі бірнеше сағаттың ішінде өлімге алып келетін назофаронгиттен басталып бірден сепсиске дейін ауытқиды.
Аурудың ауа-тамшылы жолдары арқылы беріледі (жөтелгенде, түшіргенде, сөйлескенде).
Менингококтың алғашқы белгілері суық тигенге ұқсас болып келеді (жоғарғы температура, бас ауруы).
Аурудың егжей-тегжейлі көрінісі пайда болған кезде, медициналық көмекке уақтылы жүгінбесе, өлім-жітім 50% - дан асады.
Негізгі клиникалық көріністерге мыналар жатады: дене температурасының күрт жоғарылауы 39,0°C және одан жоғары, төзімсіз бас ауруы, бұрын жүрек айнусыз құсу, жеңілдік әкелмейді, геморрагиялық бөртпе, тыныс алудың бұзылуы, тежелу, сананың шатасуы.
Науқастар немесе белгілерсіз тасымалдаушылары бар адамдар айналасындағылар үшін инфекция көзі болып табылады. Бір науқасқа 20 мыңға дейін тасымалдаушы келеді.
Менингококк инфекциясының жиілігі маусымдылықпен сипатталады-ең жоғары жиілік қыста және ерте көктемде болады.
Бұл адамның иммундық жүйесі осы уақытта көптеген вирустармен әлсірегендіктен болады, олар жылдың осы уақытында да белсендіріледі-ЖРВИ, тұмау және т. б.
Көбінесе 5 жасқа дейінгі балалар, иммундық жүйенің қалыптаспауына байланысты және жасөспірімдер мен жастар аурады – бұл жастағы адамдар түнгі клубтарда көп уақыт өткізеді, олар көптеген қауіп факторларының жиынтығымен ерекшеленеді – адамдардың көптігі, темекі шегу, ортақ сусындар және т. б.
Менингококкты инфекцияның негізгі алдын алу шаралары:
1. Аурудың алғашқы белгілері пайда болған кезде,асқынып кетуді болдырмас үшін медициналық көмекке жүгіну қажет, және өзін-өзі емдеумен айналысуға болмайды;
2. Адам көп жиналатын жерлерге бармау керек;
3. Аурып қалмау үшін және айналаданғы адамадарға ауру жұқтырмау үшін, мұрын-жұтқыншақтарының жедел және созылмалы ауруларды (фарингит, тонзилит, ларингит) уақтылы емдеу керек;
4. Таза ауада серуендеу керек, қоғамдық көліктермен жүрмеуге тырысу керек;
5. Витаминдер мен микроэлементтермен байытылған толық және теңдестірілген тамақтану, спортпен шұғылдану, ағзаны шынықтыру иммунитттің жоғарлауына ықпал етеді;
6. Үй-жайларды жиі желдету, күніне кемінде 2 рет дымқыл тазалау жүргізу керек;
7. Жөтелген кезде, түшкірген кезде бір реттік орамал пайдалану керек;
8. Жеке гигиенаны сақтау, қолды сабынмен және сумен кем дегенде 20 секунд мұқият және жиі жуу керек.
Өкінішке орай, көптеген ата-аналар аурудың қауіптілігін толық түсінбейді, сондықтан білікті медициналық көмектен бас тартады.
Менингококк инфекциясы ауруының кенеттен басталуын және ауырлығын ескере отырып, оның алғашқы белгілерінде мүмкіндігінше ертерек дәрігерден көмек сұрау қажет, бұл баланың, жасөспірімнің өміріне байланысты болады. Менингит ең қауіпті инфекциялардың ондығына кіреді, сақ болыңыз.
Ш.Айдарова,
Аудандық СЭББ-ың басқарма басшысы
Аудандық СЭББ-ың басқарма басшысы




